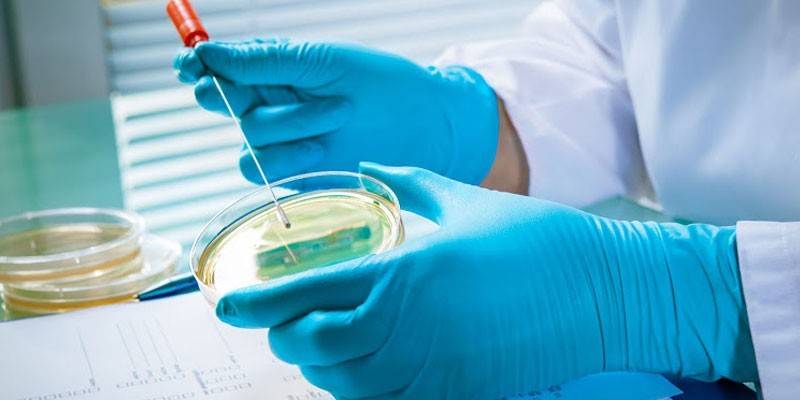

Siew na florę i wrażliwość na antybiotyki - wskazania, przygotowanie, pobieranie próbek i interpretacja
Informacyjną metodą badań laboratoryjnych jest rozmazanie flory. Zgodnie z wynikami możliwe jest zdiagnozowanie procesu zapalnego na wczesnym etapie kursu, określenie charakteru patogennego patogenu i skuteczne środki do jego zwalczania. Ważne jest, aby wiedzieć, czym jest ta metoda badawcza, jak ważna jest jej rola dla zdrowia pacjentów w różnych kategoriach wiekowych.
Co to jest bakterioza na mikroflorze
Jest to badanie laboratoryjne materiału biologicznego poprzez wysiew go na pożywce. Analiza jest konieczna do szybkiego wykrycia patogennych i warunkowo patogennych mikroorganizmów, określając schemat produktywnego leczenia. Ginekolog wykonuje pobieranie materiału biologicznego z pochwy, szyjki macicy (dla kobiet), urologa - z zewnętrznego otwarcia cewki moczowej (u mężczyzn). Otrzymaną próbkę nakłada się na sterylne szkło, suszy i przesyła do laboratorium do dalszych badań pod mikroskopem. Lekarz wykonuje pobieranie biomateriałów na ogniskach patologii.
Kultura bakteriologiczna jest uważana za metodę kulturową. Aby określić odpowiedź flory chorobotwórczej na leki, materiał biologiczny umieszcza się w klimacie sprzyjającym potencjalnym patogenom. Pożywkę selektywną stosuje się do hodowli bakterii jelitowych, tioglikolowe i Saburo uważa się za uniwersalne. Siew pomaga przeprowadzić jakościową i ilościową analizę składu flory, ponieważ mikroorganizmy są barwione w różnych kolorach. W ten sposób zwiększa się zawartość informacyjna metody, przyspieszając diagnozę. Inne przykłady:
- Koagulowana surowica końska pomaga zidentyfikować rodzaje bakterii, które powodują błonicę.
- Sole żółciowe identyfikują patogeny, które powodują ostre zaburzenia jelitowe.
- Różnicowe środowiska diagnostyczne są niezbędne do odkodowania kultury bakteryjnej.
Co jest potrzebne
Terapeutycznym celem zaszczepienia bakteriami flory jest terminowe wykrycie zwiększonej aktywności i rozprzestrzeniania się patogennych infekcji w ciele, wybranie leków, które mogą całkowicie zniszczyć patogenną florę i przywrócić zdrowie pacjenta. Analiza bakteriologiczna jest często przeprowadzana w następujących obszarach współczesnej medycyny:
- Ginekologia Zgodnie z wynikami badań określa się skład mikroflory pochwy, obecność leukocytów, czerwonych krwinek w wydzielinie, charakter czynników wywołujących choroby przenoszone drogą płciową.
- Otolaryngologia. W przypadku częstego kataru i nawracającego zapalenia migdałków wykonuje się rozmaz na florze z nosa i tylnej ściany gardła, migdałków, aby określić charakter patogenu i antybiotyku do jego eksterminacji.
- Onkologia Rozmaz na onkocytologii określa proces zapalny, obecność komórek rakowych i ich liczbę, obecność nowotworów złośliwych i inne zmiany w strukturze komórek błony śluzowej narządów płciowych kobiety.
- Traumatologia, chirurgia. Aby wykluczyć ropienie i ropnie, zawartość powierzchni rany bada się pod mikroskopem. Po zidentyfikowaniu zarazków łatwiej jest wybrać antybiotyk do ich leczenia.
Jeśli podejrzewasz proces zapalny w narządach miednicy, lekarze przepisują siew na florę. Wśród wad badania laboratoryjnego jest długie oczekiwanie na wyniki od 3-5 dni do kilku tygodni, w zależności od patogenu. Aby wyjaśnić diagnozę, lekarz przepisze reakcję łańcuchową polimerazy (PCR) lub test immunoenzymatyczny (ELISA). Po lub w tym samym czasie zaleca się antybiotykogramy w celu określenia odporności mikroorganizmów na niektóre leki przeciwbakteryjne. W rzeczywistości jest to siew wrażliwości na antybiotyki.

Wskazania
Wykonywanie sadzenia na flory jest ważnym elementem kompleksowej diagnozy, przyspiesza ostateczną diagnozę. Główne odmiany badanej metodologii:
- wysiew moczowo-płciowy;
- siew na flory z otwartej rany;
- tylny siew z nosa, ucha, gardła, oczu;
- wysiew moczu, mleka, żółci, nasienia, kału;
- Pieczenie na gronkowcach, ureaplasma, mykoplazmach, chlamydiach.
Pieczenie flory odbywa się w urologii i ginekologii z podejrzeniami zakaźnych i zapalnych narządów miednicy, na przykład z zapaleniem jelita grubego, zapaleniem miedniczno-otrzewnowym, zapaleniem błony śluzowej macicy, zapaleniem przydatków. W onkologii takie badanie sprawdza obecność komórek rakowych; w otolaryngologii ujawnia infekcje jamy ustnej i gardła. Zgodnie z wynikami badań laboratoryjnych można określić następujące szkodniki:
- drobnoustroje niespecyficzne: E. coli, enterobakterie, Klebsiella, mikroorganizmy hemofilne;
- drobnoustroje beztlenowe: pyogenne ziarniaki, rzęsistki, chlamydie, ureaplasma, mykoplazm, gonokoki;
- zakażenie gronkowcem;
- grzyby drożdżopodobne.
Biomateriał
Do siewu na florę można pobierać dowolny płyn biologiczny od mężczyzny i kobiety. Biomateriał dla wszystkich kategorii pacjentów może być:
- śluz z nosogardzieli;
- wydzielina z pochwy;
- próbka kału;
- wydzielina z kanału szyjki macicy, cewki moczowej;
- plwocina z płuc;
- zawartość torbieli, ropnych zatok itp.;
- krew
- mocz
- nasienie (ejakulat);
- zawartość ran, inne ogniska patologii skóry.
Analiza siewu
Badania biologiczne są szczególnie ważne dla przyszłych matek. Ogrodzenia materiału biologicznego są pobierane z dróg rodnych, gardła i nosa. Są to niezbędne przy planowaniu ciąży. Siew na florę i wrażliwość na antybiotyki dla kobiet w ciąży odbywa się zgodnie z tym harmonogramem: pierwszy raz przy rejestracji, drugi raz - w 36 tygodniu położniczym.
W przypadku innych kategorii pacjentów rozmaz na florze jest przepisywany wyłącznie z przyczyn medycznych (jeśli podejrzewa się, że jedna lub druga choroba wykrywa czynniki zakaźne). Aby uzyskać informacyjny i wiarygodny wynik testu laboratoryjnego, pacjent musi postępować zgodnie z prostymi zaleceniami i zaleceniami specjalisty.
Przygotowanie
3-4 tygodnie przed badaniem laboratoryjnym lekarze zalecają całkowite zaprzestanie przyjmowania antybiotyków, w tym do stosowania miejscowego. Inne środki przygotowawcze zależą od konkretnego przypadku klinicznego i obszaru materiału biologicznego do dalszych badań:
- Jeśli podejrzewasz zapalenie zatok podczas wykonywania rozmazu na florze z kanału nosowego i gardła, nie zaleca się mycia zębów, płukania nosa, picia i jedzenia rano. Wstępne podawanie antybiotyków jest zabronione.
- Przed pobraniem moczu wymagane są procedury higieniczne; zaleca się zbieranie kału rano specjalną szpatułką dostarczaną ze sterylnym jednorazowym pojemnikiem. Przed przystąpieniem do testu zabronione jest stosowanie środków przeczyszczających, w celu wykonania lewatyw czyszczących.
- Śluz z VDP jest zbierany rano na pusty żołądek, ale przed pobraniem materiału biologicznego na florę należy umyć zęby i przepłukać usta przegotowaną wodą.
- W badaniu mleka kobiecego najpierw należy przepompować 20 ml, a następnie 5 ml, aby wziąć pod następne badanie pod mikroskopem. Należy najpierw przestrzegać higieny sutków, przetrzeć otoczkę alkoholem medycznym.
- Jeśli do wysiewu konieczne jest wydzielina z pochwy, materiał biologiczny nie jest wykorzystywany podczas menstruacji. Lekarze radzą poczekać 2 tygodnie po zakończeniu miesiączki. Przed pobraniem biomateriału nie zaleca się płukania genitaliów.
- Mężczyzna przed zrobieniem wymazu z flory nie jest zalecany do oddawania moczu przez 5 godzin poprzedniego dnia, przez 2 tygodnie odradza się stosowanie antybiotyków, czasowe porzucanie alkoholu.
- Kobiety nie powinny stosować kremów, czopków, żeli dopochwowo przed pobraniem biomateriału na florę. Przed rozpoczęciem badań laboratoryjnych ważne jest przeprowadzenie toalety zewnętrznych narządów płciowych. Te zasady dotyczą także mężczyzn.
Ogrodzenie biomateriałowe
Aby uzyskać wiarygodny wynik badania, lekarze zalecają podejście do procedury siewu na flory ze szczególną odpowiedzialnością. Poniżej przedstawiono cenne zalecenia dotyczące właściwego zbierania, przechowywania i transportu materiału biologicznego:
- Specjalista pobiera płyn z ognisk zapalnych i wymagane są sterylne naczynia i narzędzia. W przeciwnym razie wynik będzie fałszywy, pacjent będzie musiał ponownie wykonać test.
- Mocz i krew są zbierane tylko w suchych probówkach, innych płynach - w specjalnych pojemnikach umieszczonych w takich pożywkach.
- W przypadku pobierania próbek materiału w domu, należy go niezwłocznie dostarczyć do laboratorium. Podczas suszenia i zmiany kwasowości flora umiera.
- Mocz należy dostarczyć do laboratorium w ciągu 2 godzin od momentu pobrania, kał powinien pozostać ciepły. Konieczne jest dostarczenie kału w ciągu 5 godzin; nie wolno najpierw przechładzać i zamrażać.
- Plwocinę do badania mikroskopowego należy przynieść w ciągu 1 godziny, w przeciwnym razie mikroflora umrze. Flora mleka matki utrzymuje żywotność nie dłużej niż 2 godziny.
Badania bakteriologiczne mikroflory w laboratorium
Czas trwania siewu zależy od charakteru patogennego patogenu i złożoności konkretnego przypadku klinicznego. Diagnoza trwa średnio 2-3 dni, ale może potrwać nawet kilka tygodni.Zgodność ze wszystkimi etapami badania laboratoryjnego jest bardzo ważna, w przeciwnym razie wynik nie będzie wiarygodny. Oto przykład wysiewu na mikroflorę pochwy:
- Biomateriał umieszcza się w sterylnym pojemniku z medium transportowym, które wspiera żywotność bakterii przez 3 dni.
- Materiał przesiewa się w specjalnym pożywnym klimacie, umieszcza w termostacie o temperaturze 37 stopni (są to najbardziej wygodne warunki do szybkiego rozmnażania się bakterii).
- Sprawdź ekspandowane kolonie: sprawdź kształt, kolor i gęstość kultury, policz liczbę (jedna komórka drobnoustrojowa w medycynie jest uważana za jednostkę tworzącą kolonię).
- Następnie rozszerzone kolonie umieszcza się w różnych środowiskach, aby zidentyfikować naturę patogennego patogenu.
- W ten sposób gatunek jest identyfikowany, wykrywana jest podatność drobnoustrojów chorobotwórczych na różne antybiotyki.
- Aby wyjaśnić naturę patogenu i właściwy wybór skutecznej terapii przeciwbakteryjnej, oprócz badania kolonii wykonuje się dodatkowo antybiotykogram.

Rozszyfrowanie wyników
Mikroflora saprofityczna w hodowli bakteryjnej z wysokim stężeniem ziarniaków wskazuje na proces zakaźny w układzie moczowo-płciowym. Aby zapewnić szczegółową interpretację wyników siewu flory, podano cztery stopnie zanieczyszczenia bakteriami. Krótki opis każdego z nich:
- Pierwszego stopnia. Powolny wzrost flory bakteryjnej występuje wyłącznie na płynnym podłożu.
- Drugi stopień Wzrost flory, składającej się z 10 kolonii, występuje tylko w gęstym środowisku.
- Trzeci stopień Mikroflora zawiera 10–100 kolonii, których wzrost obserwuje się na stałym podłożu odżywczym.
- Czwarty stopień. Mikroflora licząca 100 lub więcej kolonii rośnie wyłącznie na stałych podłożach.
Pierwsze dwa stopnie zanieczyszczenia bakteryjnego wskazują na „skażoną mikroflorę”. Trzeci i czwarty sygnalizują przebieg procesu zapalnego wywołanego przez jeden lub inny patogen patogenny. Zadanie lekarza prowadzącego: po określeniu szkodnika słuszne jest wybranie leczenia z udziałem antybiotyków, aby stłumić wzrost flory chorobotwórczej.

